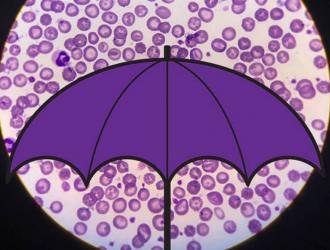

Poter rintracciare l'origine di un alimento è fondamentale per garantire la sicurezza del consumatore. La tracciabilità “documentale” tuttavia può essere aggirata ed è quindi necessario avere a disposizione strumenti di verifica indipendenti.
In un articolo da poco pubblicato su Food Chemistry,...